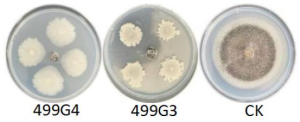

A group from Division of Infectious Diseases and Vaccinology, School of Public Health, University of California, Berkeley, CA, USA, etc. has reported about key antiviral pathways in SARS-CoV-2 infection.
https://www.nature.com/articles/s41588-022-01131-x
Recent loss-of-function (LOF) screens have begun defining host factor requirements for SARS-CoV-2 infection, these studies employed host gene knockout (KO) approaches either in nonepithelial cell lines or in cell lines that do not endogenously express ACE2 and TMPRSS2. Although LOF screens can be powerful for the identification of proviral genes, gain-of-function (GOF) screens can identify antiviral factors that mediate viral restriction upon upregulation. Performing screens in a bidirectional manner can therefore illuminate host pathways with bimodal roles and provide a more comprehensive view of viral dependencies and potential targets for host-directed therapeutic development.
From these screening results, it was found that G-protein-coupled receptor (GPCR) signaling, transcriptional regulation (TAF7L, FOXE1, ZNF275, TEAD3, SPDEF, JDP2), cell-cycle regulation (CCNE1) and mucin glycosylation (MUC1, MUC4, MUC13, MUC21, B3GNT8) are key antiviral pathways in SARS-CoV-2 infection.
To determine the impact of membrane-anchored mucins on infection of diverse SARS-CoV-2 clinical isolates, we infected our MUC1 and MUC4 GOF Calu-3 lines with alpha, beta, gamma, epsilon, delta, and WA/1 variants. It was found that overexpression of either MUC1 or MUC4 restricted viral replication of diverse SARS-CoV-2 variants relative to NTG controls. Next, mucin-selective protease (StcE) treatment followed by infection with these same variants rendered Calu-3 cells significantly more permissive to viral infection. These data suggest that membrane-anchored mucins restrict infection of multiple SARS-CoV-2 variants.